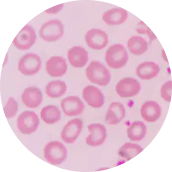

Jaundice
Πώς σχετίζεται με τη χολερυθρίνη
Τι είναι ο ίκτερος
Ο ίκτερος είναι μια πάθηση που εκδηλώνεται με κιτρίνισμα του δέρματος και του λευκού σημείου του ματιού. Ακόμη και τα υγρά του σώματος μπορεί να είναι κίτρινα. Το χρώμα του δέρματος και του λευκού μέρους του ματιού ποικίλει αναλόγως του επιπέδου της χολερυθρίνης, μιας ουσίας που βρίσκεται στο αίμα. Οι μέτριες τιμές της στον οργανισμό οδηγούν σε κίτρινο χρώμα, ενώ οι πολύ υψηλές σε καφέ. Ο ίκτερος μπορεί να εμφανιστεί από τη βρεφική ηλικία έως και σε ηλικιωμένους ανθρώπους. Συνήθως είναι ένδειξη μιας συνυπάρχουσας πάθησης στον οργανισμό (στο συκώτι ή στο έντερο ή στο χοληδόχο πόρο).
Ο νεογνικός ίκτερος συμβαίνει λόγω της περίσσειας ποσότητας χολερυθρίνης στο αίμα, ένα κίτρινο συστατικό στα ερυθρά αιμοσφαίρια. Είναι πολύ συνηθισμένος στα νεογνά, ειδικά σε αυτά που έχουν γεννηθεί πρόωρα και σε αυτά που θηλάζουν. Δεν απαιτείται πάντα θεραπεία για τον ίκτερο.
Υπάρχουν 3 τύποι:
- Ο ηπατοκυτταρικός ίκτερος - οφείλεται σε ασθένεια του ήπατος ή τραυματισμό
- Ο αιμολυτικός ίκτερος- οφείλεται σε αυξημένη παραγωγή χολερυθρίνης
- Ο αποφρακτικός ίκτερος- οφείλεται σε απόφραξη στο χοληδόχο πόρο
ΙΚΤΕΡΟΣ
Συμπτώματα και αίτια ίκτερου
Ο ίκτερος οφείλεται στη διαταραχή της λειτουργίας της χολερυθρίνης στο αίμα. Υπάρχουν πολλά πιθανά αίτια πρόκλησης του ίκτερου στους ενήλικες, μερικά από τα οποία είναι πολύ σοβαρά.
![Πέτρα στη χολή]()
Πέτρα στη χολή
![Παγκρεατίτιδα]()
Παγκρεατίτιδα
![Ηπατίτιδα]()
Ηπατίτιδα
![Δρεπανοκυτταρική αναιμία]()
Δρεπανοκυτταρική αναιμία
Το συκώτι παράγει τη χολή, ένα ένζυμο που βοηθά στην πέψη. Η συζευγμένη χολερυθρίνη εισέρχεται στη χολή και στη συνέχεια, απεκκρίνεται από το σώμα. Αυτός ο τύπος χολερυθρίνης δίνει το καφέ χρώμα στα κόπρανα. Αν υπάρχει πολλή χολερυθρίνη, διαχέεται στους περιβάλλοντες ιστούς. Αυτό είναι γνωστό ως υπερχολερυθριναιμία και ευθύνεται για το κίτρινο χρώμα στα μάτια και στο δέρμα.
Ο νεογνικός ίκτερος εκδηλώνεται με κίτρινο χρώμα του δέρματος του μωρού και του λευκού μέρους του ματιού και εμφανίζεται από τη 2η έως την 4η μέρα της γέννησης. Πολλά νεογνά εμφανίζουν ίκτερο. Σε κάποιες περιπτώσεις, υπεύθυνη για τον ίκτερο μπορεί να είναι και κάποια άλλη διαταραχή στον οργανισμό του μωρού όπως κάποια βακτηριακή ή ιογενής λοίμωξη, εσωτερική αιμορραγία, μόλυνση του αίματος, ηπατική δυσλειτουργία, ασυμβατότητα μεταξύ του αίματος της μητέρας και του νεογνού, έλλειψη ενός ενζύμου.
Στους ενήλικες εκδηλώνεται επίσης με κίτρινο χρώμα στο δέρμα και στο ασπράδι του ματιού. Συνήθως ξεκινά από το κεφάλι και επεκτείνεται και στο υπόλοιπο σώμα. Άλλα συμπτώματα είναι η ωχρότητα κοπράνων, η φαγούρα και τα σκουρόχρωμα ούρα. Το χαμηλό επίπεδο χολερυθρίνης μπορεί να οδηγήσει σε απώλεια βάρους, ναυτία, πυελικό πόνο και εύκολη κόπωση.
Διάγνωση και εξετάσεις για τον ίκτερο
Για να γίνει η διάγνωση του ίκτερου απαιτείται κλινική εξέταση από τον αρμόδιο γιατρό που είναι ο γαστρεντερολόγος. Είναι πολύ σημαντική η καταγραφή του ιατρικού ιστορικού του ασθενή και ο εργαστηριακός έλεγχος. Είναι σημαντικό να εξεταστεί το συκώτι και η περιοχή της κοιλιάς, ώστε να διαπιστωθεί αν υπάρχει κίνδυνος για κίρρωση ή καρκίνο. Συνιστάται έλεγχος της λειτουργίας του ήπατος και αιματολογικές εξετάσεις για τη μέτρηση της χολερυθρίνης.
Μερικές από τις εξετάσεις που είναι πιθανό να ζητηθούν είναι:
- Μέτρηση χολερυθρίνης στο αίμα
- Γενική εξέταση αίματος
- Έλεγχος αντισωμάτων για ηπατίτιδα Α, Β και C.
Συμπληρωματικά και κατόπιν αιτήματος του γιατρού, ενδέχεται να χρειαστεί περαιτέρω διερεύνηση με ακτινογραφία, υπέρηχο ή μαγνητική τομογραφία.
Στην περίπτωση του νεογνικού ίκτερου η διάγνωση γίνεται συνήθως από την κλινική εικόνα του νεογνού, δηλαδή είναι εμφανής στο χρώμα του δέρματός του. Ο παιδίατρος θα εξετάσει το νεογνό κάτω από έντονο φως για να διαπιστώσει αν υπάρχει ίκτερος. Σε κάθε περίπτωση όμως πρέπει να επιβεβαιωθεί με αιματολογικές εξετάσεις που περιλαμβάνουν τη μέτρηση της χολερυθρίνης.
Αντιμετώπιση και θεραπείες για τον ίκτερο
Για τον ίκτερο των ενηλίκων η αντιμετώπιση εξαρτάται από την αιτία πρόκλησης του ίκτερου, στην οποία και στοχεύει. Αν οφείλεται σε αναιμία, ο γιατρός συνήθως χορηγεί συμπλήρωμα σιδήρου και διατροφή πλούσια σε σίδηρο. Αν οφείλεται σε λοίμωξη από ηπατίτιδα χορηγείται η κατάλληλη αντιιική αγωγή ή φαρμακευτική αγωγή με στεροειδή. Ο ίκτερος που οφείλεται σε κάποιον καρκινικό όγκο αντιμετωπίζεται με τη χειρουργική αφαίρεση του όγκου. Αν οφείλεται στη λήψη κάποιων φαρμάκων, συνήθως ο γιατρός αντικαθιστά τη φαρμακευτική αγωγή με άλλη.
Τέλος, σε περιπτώσεις όπου ο ίκτερος οφείλεται σε στένωση στα χοληφόρα συνιστώνται νέες μέθοδοι, που πλέον έχουν αντικαταστήσει την κλασική χειρουργική επέμβαση, η ERCP (Ενδοσκοπική Παλίνδρομη Χολάγγειο- Παγκρεατογραφία) και ο EUS (Ενδοσκοπικός Υπέρηχος). Κατά τις επεμβάσεις αυτές τοποθετείται από τον εξειδικευμένο γαστρεντερολόγο ένα stent για να παροχετευθεί η χολή στο λεπτό έντερο. Είναι σημαντικό να ενημερωθείς από πριν την επέμβαση από το γιατρό σου για την ειδική προετοιμασία, αλλά και τι θα πρέπει να προσέξεις πριν την προγραμματισμένη εξέταση και επέμβαση.
Ο νεογνικός ίκτερος δεν χρειάζεται πάντα αντιμετώπιση. Σε κάποιες περιπτώσεις υποχωρεί από μόνος του μέσα σε 2-3 εβδομάδες. Για μέτριο ή πιο σοβαρό ίκτερο, το νεογνό θα πρέπει να παραμείνει στο μαιευτήριο για όσο διάστημα ορίσει ο θεράπων γιατρός. Οι υπάρχουσες θεραπείες που στοχεύουν στη μείωση του επιπέδου της χολερυθρίνης στο αίμα είναι η φωτοθεραπεία (το μωρό τοποθετείται κάτω από μια ειδική λάμπα- απαιτείται προστασία των ματιών του παιδιού με ειδικά γυαλιά), σε κάποιες περιπτώσεις όπου ο ίκτερος σχετίζεται με τη διαφοροποίηση της ομάδας αίματος της μητέρας από το νεογνό μπορεί να εφαρμοστεί μια φαρμακευτική αγωγή με πρωτεινη που στοχεύει στη μείωση του επιπέδου των αντισωμάτων στον οργανισμό, ενώ σε πιο βαριά και σπάνια περιστατικά, όπου το νεογνό δεν ανταποκρίνεται σε καμία άλλη θεραπεία, η μετάγγιση αίματος.
Κόστος θεραπείας για τον ίκτερο
Το κόστος της θεραπείας του ίκτερου εξαρτάται από την αιτία πρόκλησης και από τη θεραπεία που θα χρειαστεί να λάβει ο ασθενής. Ο αρμόδιος γιατρός για τον ίκτερο σε ενήλικες είναι ο γαστρεντερολόγος, ενώ σε νεογνά ο παιδίατρος. Συνήθως η διάγνωση τίθεται εντός μαιευτηρίου και το μωρό μπορεί να παραμείνει για περισσότερες μέρες σε νοσηλεία.
Average cost and price range
Average service cost
From
doctors
Price range for all areas
Συμβουλές για τον ίκτερο
Όλα με μέτρο και χωρίς υπερβολές!
Ο ίκτερος σχετίζεται με την ηπατική λειτουργία. Αυτό σημαίνει ότι είναι σημαντικό να διατηρήσεις την υγεία του ήπατος σε καλή κατάσταση.
Φάε υγιεινά
Η ισορροπημένη διατροφή θα βοηθήσει το συκώτι σου να λειτουργεί σωστά και δεν θα το επιβαρύνει περιττές τοξίνες και βλαπτικές ουσίες. Η μεσογειακή διατροφή είναι η ιδανική για τη διατήρηση της καλής υγείας σου.
Ασκήσου με συστηματικότητα
Δεν είναι ανάγκη να γυμνάζεσαι πολλές ώρες και έντονα. Λίγες ώρες άσκησης εβδομαδιαίως σε ήπιο ρυθμό αρκούν για να βοηθήσουν τις λειτουργίες του σώματός σου να δουλεύουν... ρολόι!
Μην υπερβάλλεις με το αλκοόλ
Το αλκοόλ θα πρέπει να καταναλώνεται πάντα με μέτρο. Δεν χρειάζεται σε κάθε περίπτωση να απέχει κάποιος εντελώς από αυτό, όμως είναι σημαντικό να τηρείται πάντα σωστό μέτρο.
Στην περίπτωση του νεογνικού ίκτερου, οι συμβουλές πρόληψης είναι διαφορετικές. Συνιστάται να ταΐζεις το μωρό σου συχνότερα. Αν θηλάζεις θα πρέπει να τρώει 8-12 φορές την ημέρα για τις πρώτες μέρες. Σε κάποιες περιπτώσεις, ο γιατρός μπορεί να συστήσει συμπλήρωμα γάλακτος, αν το παιδί χάνει βάρος και δεν αρκεί το γάλα θηλασμού.
Συχνές ερωτήσεις σε γιατρούς για τον ίκτερο
Ο ίκτερος στους ενήλικες πρέπει σε κάθε περίπτωση να εξετάζεται διεξοδικά, καθώς συνήθως υποκρύπτει κάποιο πρόβλημα στο αίμα ή στο συκώτι. Ο νεογνικός ίκτερος συνήθως δεν είναι κάτι ανησυχητικό και πολλές φορές δεν χρειάζεται καν θεραπεία, γιατί υποχωρεί από μόνος του. Αν το νεογνό είναι έντονα κίτρινο, έχει υπνηλία ή είναι πολύ ανήσυχο, δεν τρώει αρκετά, χάνει βάρος ή έχουν περίεργο χρώμα οι κενώσεις του θα πρέπει να απευθυνθείς άμεσα σε παιδίατρο.
Αν ένα νεογνό παρουσιάζει ίκτερο, η θηλάζουσα μαμά θα πρέπει να θηλάζει το μωρό ακόμη συχνότερα (περίπου 8-12 φορές ημερησίως). Αν το μωρό, με το μητρικό γάλα παρουσιάζει έντονη απώλεια βάρους και ο ίκτερος είναι υψηλός, τότε ίσως χρειαστεί να χορηγηθεί και ξένο γάλα ως συμπλήρωμα για να μειώσει τις τιμές της χολερυθρίνης.
Ναι, τα αυξημένα επίπεδα χολερυθρίνης στο αίμα μπορεί να προκαλέσουν πυρετό, ναυτία, εμετούς, απώλεια βάρους ή ακόμη και πυελικό πόνο. Σε κάθε περίπτωση θα πρέπει να απευθυνθείς άμεσα σε γιατρό για να σου δώσει οδηγίες αντιμετώπισης.